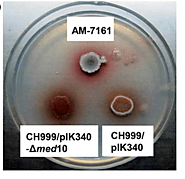

-
About
- About Listly
- Community & Support
- Howto
- Chrome Extension
- Bookmarklet
- WordPress Plugin
- Listly Premium
- Privacy
- Terms
- DMCA Copyright
- © 2010-2025 Boomy Labs

Listly by Atiriya Mungal
Let's dive into the species' most natural form.

Streptomyces bacillaris is a bacterium species that belongs to the Phylum Actinomycetota. It belongs to the family Streptomycetaceae and Genus Streptomyces.

Streptomyces bacillaris is predominantly found in the soil. Some scientists have managed to find it in aquatic environments aswell. This particular species is found in forest soil in Oregon in the United States. It is known for its antifungal properties.

Streptomyces bacillaris S8 was tested as an antifungal to boost Soybean crop yield due to the fact that it produces Valinomycin. The strain was proven to be effective against Collectotruchum truncatum and Fusarium sp.
Lactoquinomycin A or Medermycin is an antibiotic made from Streptomyces bacillaris. It is known to work against Gram positive bacteria, especially the Methicillin resistant Staphylococcus aureus which is a well known human pathogen.

Streptomyces bacillaris is a Gram-positive bacterium that is filamentous or rod shaped. It is Aerobic.

While it is common knowledge that Fungi are decomposers along with Bacteria, Fungi can also be pathogenic to multiple plant species. The overgrowth of mold on soil causes an accumulation of mycotoxins rendering the soil "Too Toxic" to provide a good habitat for almost any plant species. Both plants and animals would die as a result.

Streptomyces bacillaris is able to produce Valinomycin, an antibiotic that can distrupt the potassium gradient aswell as the production of ergosterol in the cell membrane leading to death of the cell. The naturally occurring antibiotic produced by this bacterial species can inhibit the growth of several fungal species such as Aspergillus niger, also known as 'Black Mold', Candida Albicans and Cryptococcus albidus, to name a few.

Streptomyces bacillaris has a complex biosynthetic pathway that makes it difficult to apply biotechnological knowledge to. When investigating a new strain for more applications, biotechnologists need to exercise extreme caution due to the fact that Streptomyces is a highly resistant bacterial genus. If a new strain happens to be pathogenic to humans, scientists would experience numerous problems finding a bactericidal for it.